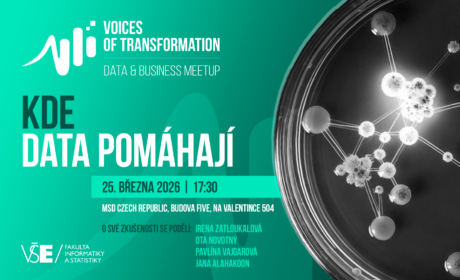
Kde data pomáhají? Přijďte to zjistit na další meetup ze série Voices of Transformation
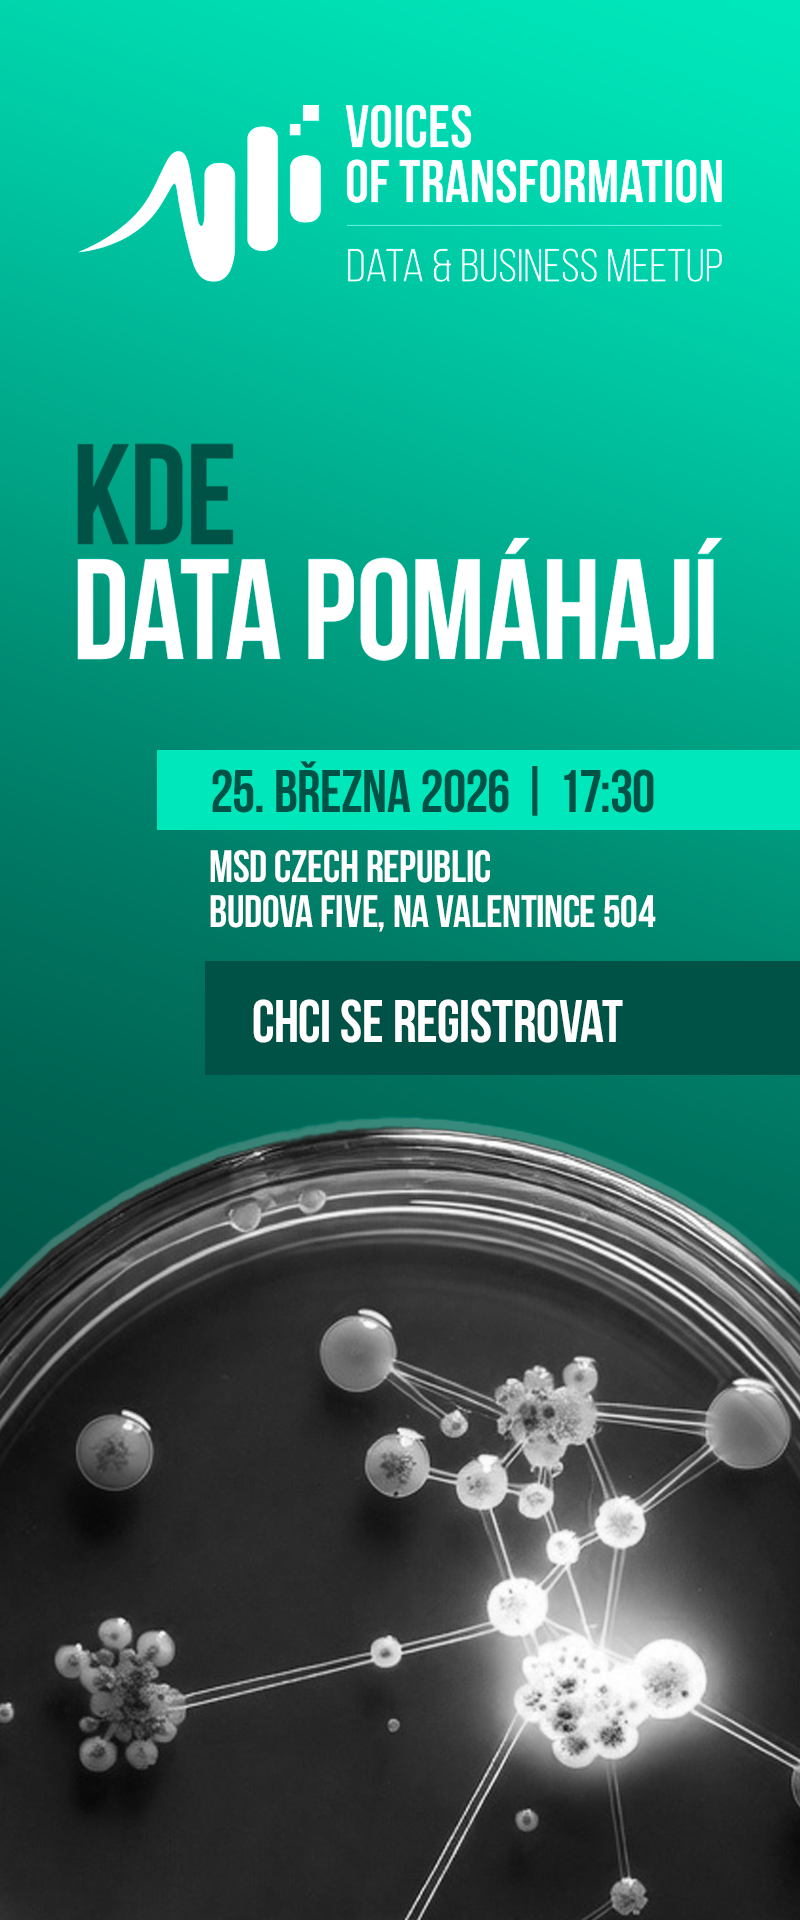
Kde data pomáhají

Studijní programy Data & Business VŠE
Novinky ze světa dat
KDO JSME
Data & Business je expertní platforma, která podporuje a zasazuje se o větší míru využití dat při manažerském rozhodování.
- Poskytuje manažerské i vysokoškolské vzdělání a konzultační služby.
- Vychází z praxe klíčových institucí v oboru a metodik předních vzdělávacích institucí.
- Úspěšně propojuje datové odborníky, manažery a decision makery v rámci networkingu, praxe i jedinečného systému vzdělávání.